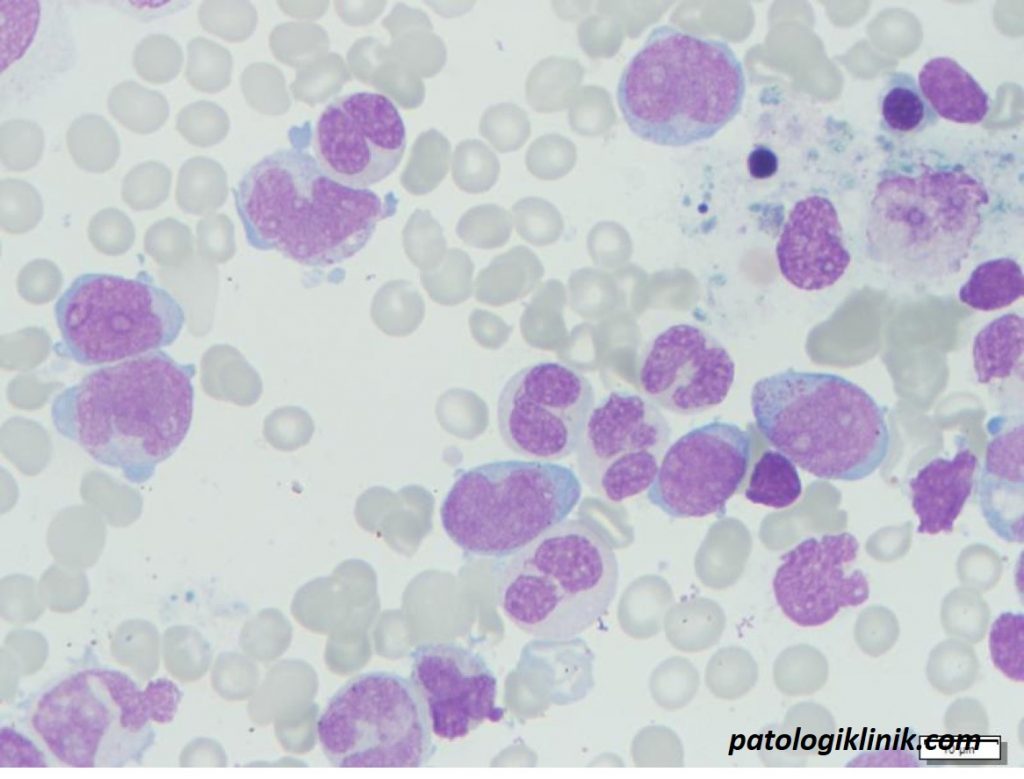

Membedakan Monosit, Promonosit, dan Monoblas

Monosit merupakan seri sel leukosit pada darah tepi dan sumsum tulang yang paling sulit diidentifikasi, baik pada orang sehat, penyakit infeksi, dan keganasan hematologi. Begitu juga membedakan monosit matur dan imatur masih menjadi kesulitan tersendiri bagi seorang SpPK, dimana monosit imatur biasanya tidak ditemukan dalam jumlah yang banyak selain pada keganasan hematologi pada jalur sel monosit. Berikut cara membedakan monosit, promonosit, dan monoblas.
Proses maturasi jalur monosit

Monosit
- ukuran 3-4 kali eritrosit
- sitoplasma lebar, rasio inti : sitoplasma rendah
- inti indentasi berbentuk seperti ginjal dengan kromatin matur
- tidak ada nukleoli
- sitoplasma lebar berwarna abu-abu sampai biru pucat, tanpa granula
- sering ditemukan vakuol pada sitoplasma

Promonosit
- ukuran 3-4 kali eritrosit
- inti bulat dengan indentasi dan kromatin imatur
- terdapat nukleoli
- sitoplasma lebih sempit dibanding monosit berwarna abu-abu sampai biru pucat, tanpa granula
- kadang ditemukan vakuol pada sitoplasma
- pada hitung jenis pasien dengan leukemia, promonosit dimasukkan pada hitung jenis sel blas (monoblas+promonosit)

Monoblas
- ukuran 3-4 kali eritrosit
- rasio inti : sitoplasma tinggi
- inti bulat, kadang ada indentasi dengan kromatin imatur
- nukleoli tampak menonjol
- sitoplasma sempit (tapi lebih lebar dibandingkan mieloblas) berwarna kebiruan sampai biru pucat, tanpa granula
- kadang ditemukan vakuol pada sitoplasma

Semoga bermanfaat.
Sumber gambar hematologyoutlines.com




![[Download] Pedoman Nasional Pelayanan Kedokteran Tata Laksana Thalassemia (KMK)](/content/images/uploads/2022/10/KMK.jpg)
![[Download] Pemeriksaan Laboratorium pada Thalassemia](/content/images/uploads/2022/09/cover-web-scaled.jpg)